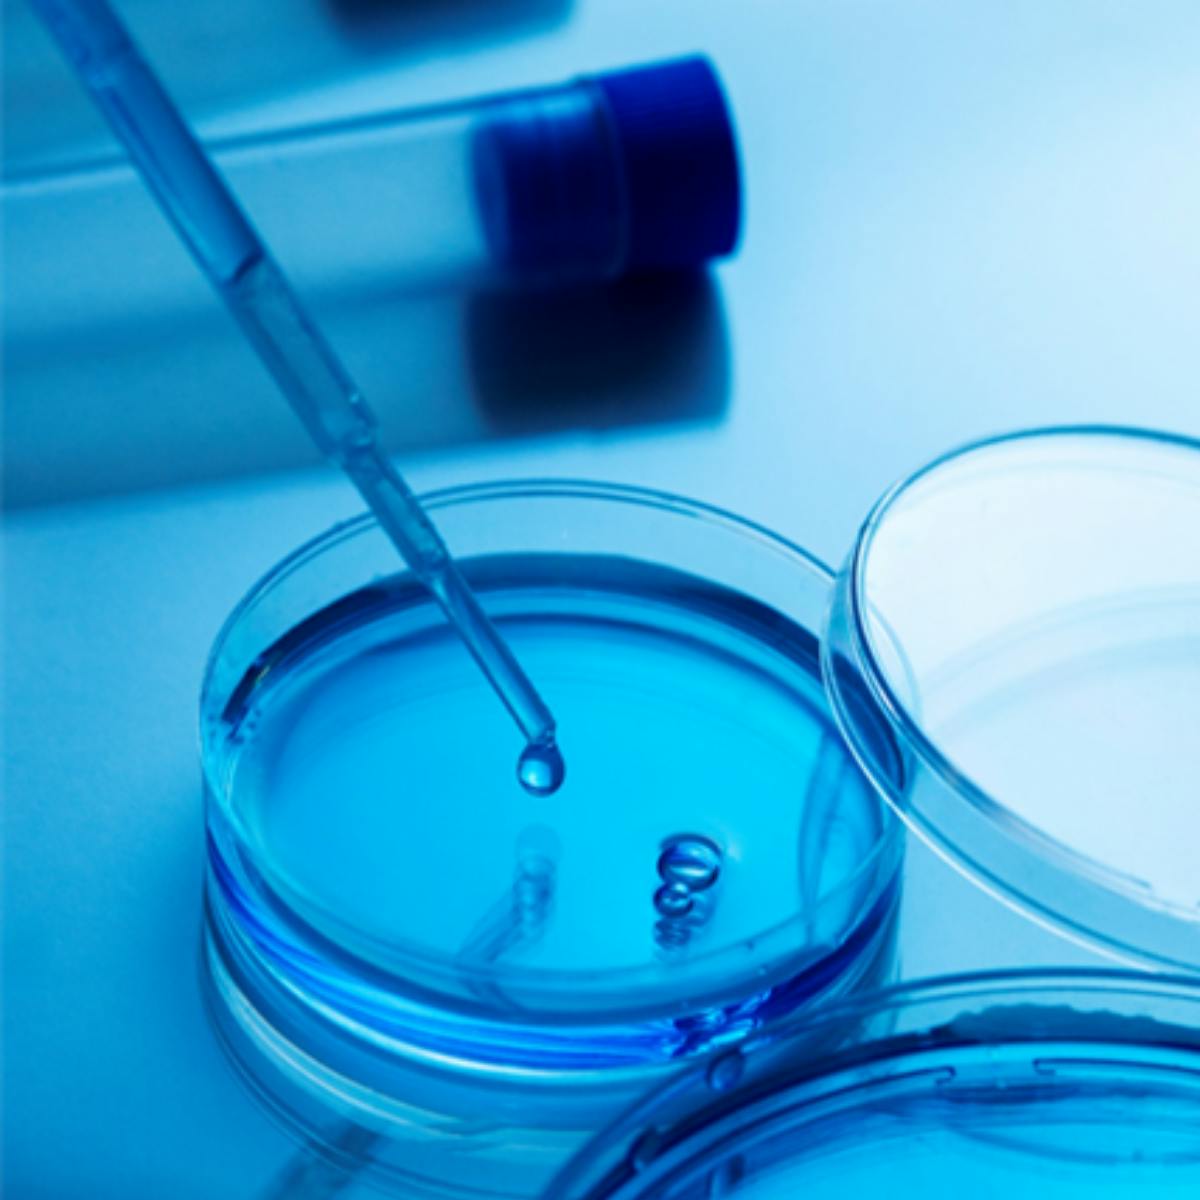

Podcasts
Podcasts•External link
AI, LABI, and How we Invest: A Conversation with Neel Madhukar, PhD and Themasap Khan, PhD
Neel Madhukar, PhD, Chief Technology Officer of Luma Group’s proprietary AI model, LABI, discusses the genesis of the program and how it impacts day-to-day processes at Luma Group. Neel and Themasap discuss what we are building at Luma Group to change the game for biotech investing.
See More